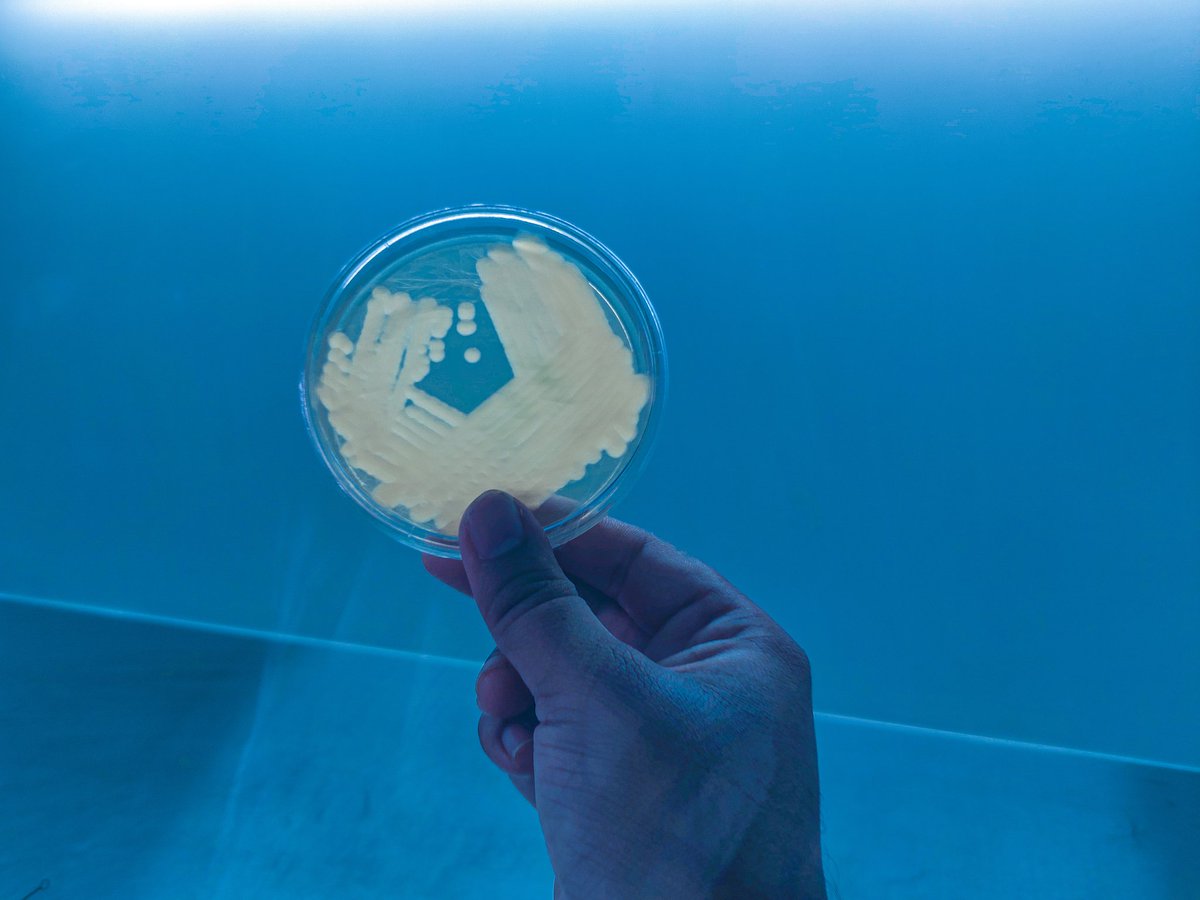
It's lazy outside the plant 🍃......Xanthomonas #Pomegranate #BacterialBlight

CrazyPlantpathologist
@crazyplantpath1
plant pathologist, crazy about plant pathogens
ID: 1229240787809947649
17-02-2020 03:07:15
50 Tweet
257 Followers
425 Following

Some flowers have learned to bounce back after injury buff.ly/3axAPgx via University of Portsmouth New Phytologist #plantscience #botany









Crop pathogens are more adaptable than previously thought via The Conversation Africa theconversation.com/crop-pathogens…



bioRxiv: RefPlantNLR: a comprehensive collection of experimentally validated plant NLRs via The Sainsbury Laboratory sco.lt/73hRpI